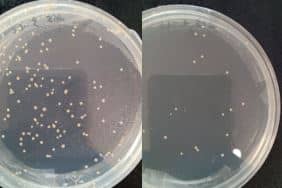
Bacterial culture plates used to evaluate the effectiveness of ultraviolet LED disinfection before and after treatment

What was the challenge or problem to be solved?
The development of a new UV-based system required validation of its real performance before market introduction. Demonstrating ultraviolet emission alone was not sufficient; its effectiveness had to be verified under representative operating conditions and aligned with the defined technical objectives.
Disinfection device for textiles and surfaces
The project originated from the need to analyse a disinfection device intended for the treatment of textiles and surfaces using ultraviolet LED technology. This type of solution aims to reduce microbial load without the use of chemical agents, offering operational advantages but also imposing stricter technical validation requirements.
In textiles, the fibrous structure generates shadowed areas and variations in actual radiation exposure. Ultraviolet light penetration depends on fabric density, colour and absorption capacity. In rigid surfaces, factors such as roughness, reflectance and micro-irregularities influence the effective dose received.
Material geometry directly affects the actual effectiveness of UV disinfection.
The initial challenge was to determine whether the system ensured homogeneous irradiation across the entire treated area and whether exposure levels were sufficient to achieve consistent disinfection. It was also necessary to assess whether repeated use could affect the physical or aesthetic properties of the materials.
Validation of germicidal efficacy in UV-LED equipment
The validation of germicidal efficacy represented a critical component of the project. In UV-LED systems, microbial inactivation capacity depends on wavelength, actual optical power, exposure distance and application time.
Considering nominal LED power alone is insufficient; it is essential to calculate the effective UV dose that actually reaches the treated surface. Minor variations in internal geometry or object positioning can significantly alter the outcome.
The objective was to establish a technical correlation between irradiance, exposure time and expected microbial reduction. This analysis made it possible to determine whether the system operated within a safe and effective range, and whether parameters needed to be redefined to improve performance without increasing energy consumption or compromising safety.
Technical optimization of the UV disinfection system
The complexity of the project lay in the interaction between ultraviolet radiation, mechanical design and material behaviour. Irradiance distribution can be affected by LED arrangement, internal geometry or the presence of elements generating partial shadows.
Additionally, balancing power and durability was relevant. Excessive dose may cause degradation due to ultraviolet radiation, colour changes or loss of mechanical properties in certain materials. Conversely, insufficient dose reduces treatment effectiveness.
INFINITIA addressed this challenge by identifying the critical factors influencing system performance, assessing their impact and establishing technical criteria for improvement through a structured, experimentally based approach.

How was it addressed or what was the solution?
The work was structured as a comprehensive technical evaluation combining experimental measurements and functional analysis of the equipment. The objective was to transform the data obtained into concrete improvement recommendations, reinforcing its positioning within innovative technological disinfection solutions.
Technical evaluation of the device through controlled testing
The first phase involved measuring emitted irradiance and calculating accumulated dose under different operating configurations. Variations in distance, exposure time and surface positioning were analysed to identify potential deviations from expected performance.
To ensure representativeness, different standard material samples were selected, including textiles and rigid surfaces, which served as experimental references. These samples were prepared and inoculated with different model bacteria such as E. coli and S. aureus, in order to simulate realistic contamination scenarios. This step was essential to ensure the relevance and applicability of the results obtained.
Microbiological validation links UV dose to real bacterial reduction.
Ultraviolet LED treatments were then applied to the inoculated samples, comparing bacterial load before and after exposure. Surviving microorganisms were quantified using culture methods and microbiological analysis techniques, including colony-forming unit (CFU) counting. This procedure enabled precise measurement of treatment efficiency and comparison between different LED configurations and wavelengths used.
In parallel, radiation uniformity across the working area was evaluated, identifying potential low-intensity zones. This analysis helped to understand how internal geometry and UV module orientation influenced final performance. Realistic usage scenarios were also considered, simulating conditions that could alter theoretical performance. This approach prevented conclusions based solely on nominal specifications and provided a more accurate understanding of system behaviour.
Optimization of the UV disinfection equipment design
Based on the experimental results, adjustments were proposed to optimize the UV disinfection equipment design. This included reviewing LED arrangement, potential redistribution of emitters and defining more suitable operating parameters.
INFINITIA’s technical team participated in data interpretation and formulated recommendations aimed at improving irradiation homogeneity. Energy efficiency and thermal management aspects were also analysed, as temperature can affect both LED performance and overall system stability.
Optimization is not about more power, but maximizing effective dose safely.
Optimization did not focus solely on increasing power, but on improving the balance between effective dose, operational safety and preservation of treated materials, seeking a technically justified equilibrium.
Technical benefits after validation of the disinfection system
Following the analysis and improvement process, a solid technical foundation was established to define optimal operating conditions. Validation reduced uncertainties associated with real performance and facilitated decision-making in subsequent development phases.
The project was considered successful after demonstrating that certain ultraviolet LED devices could effectively disinfect textiles and surfaces. Valuable information was also obtained regarding how different wavelengths influenced bacterial reduction. These results enabled the client to optimize disinfection processes, ensuring a high level of hygiene through the newly developed system.
Overall, the intervention helped transform a functional prototype into a technically validated piece of equipment, with greater control over applied effective dose and verifiable arguments supporting its efficacy in textile and surface applications